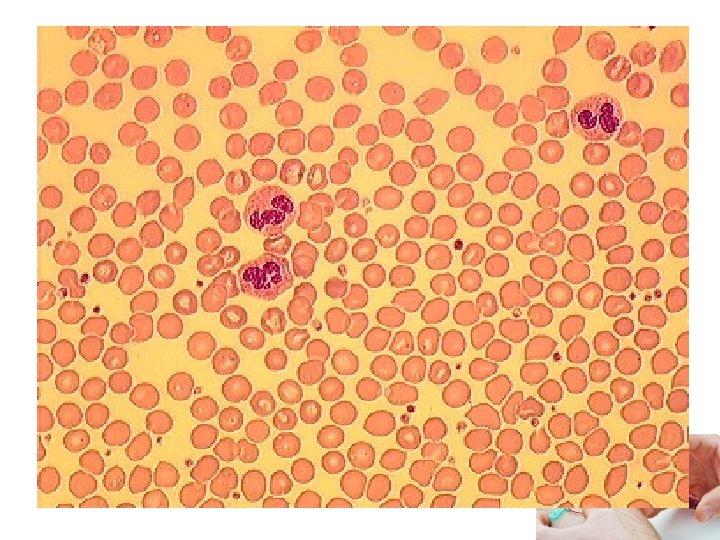

Royaume du Maroc Ministre de la Sant ISPITS

- Slides: 53
Royaume du Maroc Ministère de la Santé ISPITS de Fès Filière: Sage femme Module 2: Personne et santé sous module 4: sciences biologiques Les examens du laboratoire Enseignante responsable: Mme EL Filali Saida Enseignants associés: Mr Tabich Anas Mr Hibaoui Lahbib
Les types d’analyses biologiques
Les examens de laboratoire Les types d'analyses les plus demandés sont : les examens biochimiques, les examens hématologiques et les examens microbiologiques parasitologie). (bactériologie et
Les examens Biochimiques La biochimie est l'étude des réactions chimiques du monde vivant. Les analyses biochimiques consistent à mesurer les quantités des constituants des liquides biologiques (sang, urine, etc. ). La plupart des maladies ont en effet des répercussions sur leur composition et leur étude peut aider au diagnostic et au suivi de nombreuses maladies.
Les examens Hématologiques § Les analyses hématologiques sont pratiquées sur le sang pour permettre le diagnostic ou le suivi de certaines maladies. § Le sang est composé d'un liquide, le plasma, dans lequel flottent des cellules (globules rouges, blancs et plaquettes) et un grand nombre de substances (protéines, hormones, vitamines, etc. ). § Ainsi, l'hématologie regroupe l'analyse des cellules du sang mais aussi d'éléments dissous dans le plasma comme les facteurs de la coagulation ou les anticorps.
L’examen hématologique Les examens Hématologiques morphologique et décrire l'aspect des différentes cellules
L’examen hématologique Les examens Hématologiques morphologique et décrire l'aspect des différentes cellules quantitatif et exprimer la numération formule sanguine (NFS): Ce décompte par des globules rouges, des globules blancs et des plaquettes sanguines permet le diagnostic de très nombreuses affections
Les affections Hématologiques • Anémies: manque de globules rouges et surtout d'hémoglobine. • Infections d'origine bactérienne où les globules blancs dits neutrophiles sont augmentés. • Syndromes viraux où les globules blancs sont plutôt diminués. • Thrombopénies: manque de plaquettes entraînant un risque d'hémorragie. . .
Bactériologie / Parasitologie • En bactériologie et parasitologie, le but des analyses est souvent d'identifier l'agent responsable de l'infection : bactérie, parasite, champignons microscopiques, etc. • Elles consistent donc à prélever un échantillon et à recher l'élément pathogène soit par observation directe soit après mise en culture. L'identification du germe pathogène aidera à définir le meilleur traitement et l'antibiotique le plus efficace.
Bactériologie / Parasitologie • Elles consistent donc à prélever un échantillon et à recher l'élément pathogène: Soit par observation directe Soit après mise en culture. L'identification du germe pathogène aidera à définir le meilleur traitement et l'antibiotique le plus efficace.
Bactériologie / Parasitologie Soit par observation directe
Bactériologie / Parasitologie Soit après mise en culture:
Bactériologie / Parasitologie L'identification du germe pathogène aidera à définir le meilleur traitement et l'antibiotique le plus efficace (Antibiogramme):
Les types de prélèvements
Phase pré analytique § Le prélèvement appartient à la phase pré analytique, § Cette première phase est très importante dans l'analyse médicale, elle comprend: L'état du patient (à jeun ou non). L'étiquetage des échantillons prélevés, L'enregistrement des demandes d'analyses. § En règle générale, le patient doit éviter de prendre un repas riche en sucres ou en graisses juste avant de faire une prise de sang. § Pendant cette étape un certain nombre d'opérations peut fausser les résultats comme l'utilisation d'un tube avec un mauvais anticoagulant ou la présence d'une hémolyse.
Types de prélèvements § Prélèvements de sang veineux (au pli du coude, sur la main, à …) et artériel. § Prélèvements de selles, d'urines. § Prélèvements cutanéo-muqueux (vaginaux, urétraux, de la cavité buccale…) § Prélèvements de peaux et phanères (ongles, cheveux…) § Prélèvements de liquides d'épanchement (pleural, péritonéal, etc. ) ou de ponction (liquide céphalorachidien, moelle osseuse, etc. )
Le prélèvement veineux
Prélèvement sanguin § Un prélèvement sanguin par voie veineuse consiste à ponctionner une veine avec une aiguille appropriée afin de recueillir un échantillon de sang veineux dans un tube à prélèvement en vue de réaliser des examens biologiques.
Le prélèvement sanguin § Cette méthode de prélèvement est facile et rapide et fournit du sang en quantité suffisante pour permettre de répéter un test en cas d’erreur ou de résultats douteux, cependant elle doit être effectuée avec beaucoup de soins.
La technique § Préparer le matériel nécessaire pour effectuer le prélèvement: ü Un garrot (permettant la stase veineuse et donc le gonflement des veines) ü les tubes ü Un produit antiseptique (il s’agit d’un acte invasif, potentiellement septique) ü Le dispositif de prélèvement (aiguille + corps) ü Un pansement stérile imbibé de désinfectant ü Un pansement protecteur, ü Un plateau ü Un container à aiguilles souillées et des gants à usage unique jetables (dans le cadre de la prévention des accidents par exposition au sang)
La technique § Vérifier l’identité du malade et identifier les tubes. § Le patient doit être installé confortablement, le bras appuyé eu une surface plane. § Il doit fermer la main pour faire gonfler les veines, qui seront ainsi plus facilement palpable.
Choix de la veine
On cas d’échec!!! § On utilise les veines de la main qu’en cas d’échecs répétés du prélèvement veineux dans des régions plus hautes, car ces veines ont tendance à rouler, d’autre part, l’innervation assez riche de la face dorsale de la main rend la ponction très douloureuse.
La technique § Palper le trajet de la veine avec l’index et désinfecter le point de prélèvement. § Sérer le bras du patient au niveau du coude et tendre légèrement la peau sur la veine. § Traverser la peau dans le sens de la circulation veineuse en dirigeant la pointe de l’aiguille au centre de la veine.
La technique § L’introduction du tube dans le porte tube, § Relâcher le garrot des l’apparition de sang dans le tube et demander au malade d’ouvrir la main.
La technique § Remplir les tubes jusqu’à ce que la proportion anticoagulant/sang est adéquate. § Mélanger immédiatement chaque tube contenant un anticoagulant en renversant complétement les tubes 5 à 6 fois. § Ne pas agiter trop fortement pour éviter l’hémolyse.
La technique § Comprimer fermement la veine ponctionnée avec une compresse stérile, placer un sparadrap. § Vérifier de nouveau l’identification des tubes.
1 2 3
Le prélèvement d’urine
Le prélèvement d’urine § En règle générale, ils sont réalisés en dehors de toute antibiothérapie locale ou générale, il ne faut pas uriner avant de venir.
Intérêt § Le prélèvement des urines est un acte simple, permettant notamment de recher une infection urinaire, de déterminer le germe en cause, et de pouvoir ainsi adapter le traitement antibiotique. § Il permet aussi de recher la présence de cellules, de cristaux et de doser certains paramètres biochimiques dans les urines.
Le prélèvement d’urine § L’analyse à effectuer étant un examen bactériologique, il faut effectuer le recueil le plus "stérilement" possible. § Le prélèvement urinaire peut être réalisé par le patient au laboratoire ou à son domicile. § Seuls les flacons ou les poches stériles pourront être utilisés pour le recueil:
Le prélèvement d’urine
Les prélèvement cutanéo-muqueux
§ Ce type de prélèvement ce fait souvent par des écouvillons:
Les anticoagulants
Introduction § Lors d’une prise de sang, lorsque plusieurs tubes sont utilisés, ils ont souvent des bouchons de couleur différente. En effet, les tubes contiennent des substances différentes selon les analyses à effectuer : à chaque substance correspond un code couleur. Les tubes sont divisés en 2 grandes familles : • les tubes dits secs sans anticoagulant permettant d’obtenir du sérum. • les tubes contenant un anticoagulant permettant d’obtenir du plasma.
§ Ce tube avec bouchon rouge ne contient aucun anti coagulant, le sang va donc pouvoir coaguler dans le tube. § Après centrifugation, nous obtiendrons donc du sérum. § Ce tube servira notamment pour les analyses: ü En biochimie, ü en sérologie, ü en allergie, ü en auto-immunité, ü en hormonologie, ü pour les marqueurs en cancérologie
§ Le tube à bouchon bleu contient un anti coagulant: le citrate de sodium. § Ce tube sera utilisé pour: Ø les bilans de coagulation et Ø le suivi des traitements anti coagulants. . .
§ Le tube à bouchon violet contient un anti coagulant: l’EDTA. § Ce tube est utilisé notamment pour: Ø les numérations (globules blancs, globules rouges, plaquettes), Ø l’hémoglobine glyquée, Ø les groupes sanguins. . .
§ Le tube à bouchon vert contient un anti coagulant: l’héparine de lithium. § Ce tube est surtout utilisé pour la biochimie: § ionogramme, § urée, § créatinine, § Bilan lipidique…….
§ Le tube à bouchon noir contient un anti coagulant: Citrate de sodium. § Ce tube est surtout utilisé pour la vitesse de sédimentation.
Recommandations particulières Impératif de respecter le remplissage jusqu’au trait de jauge
La vidéo
MERCI POUR VOTRE ATTENTION